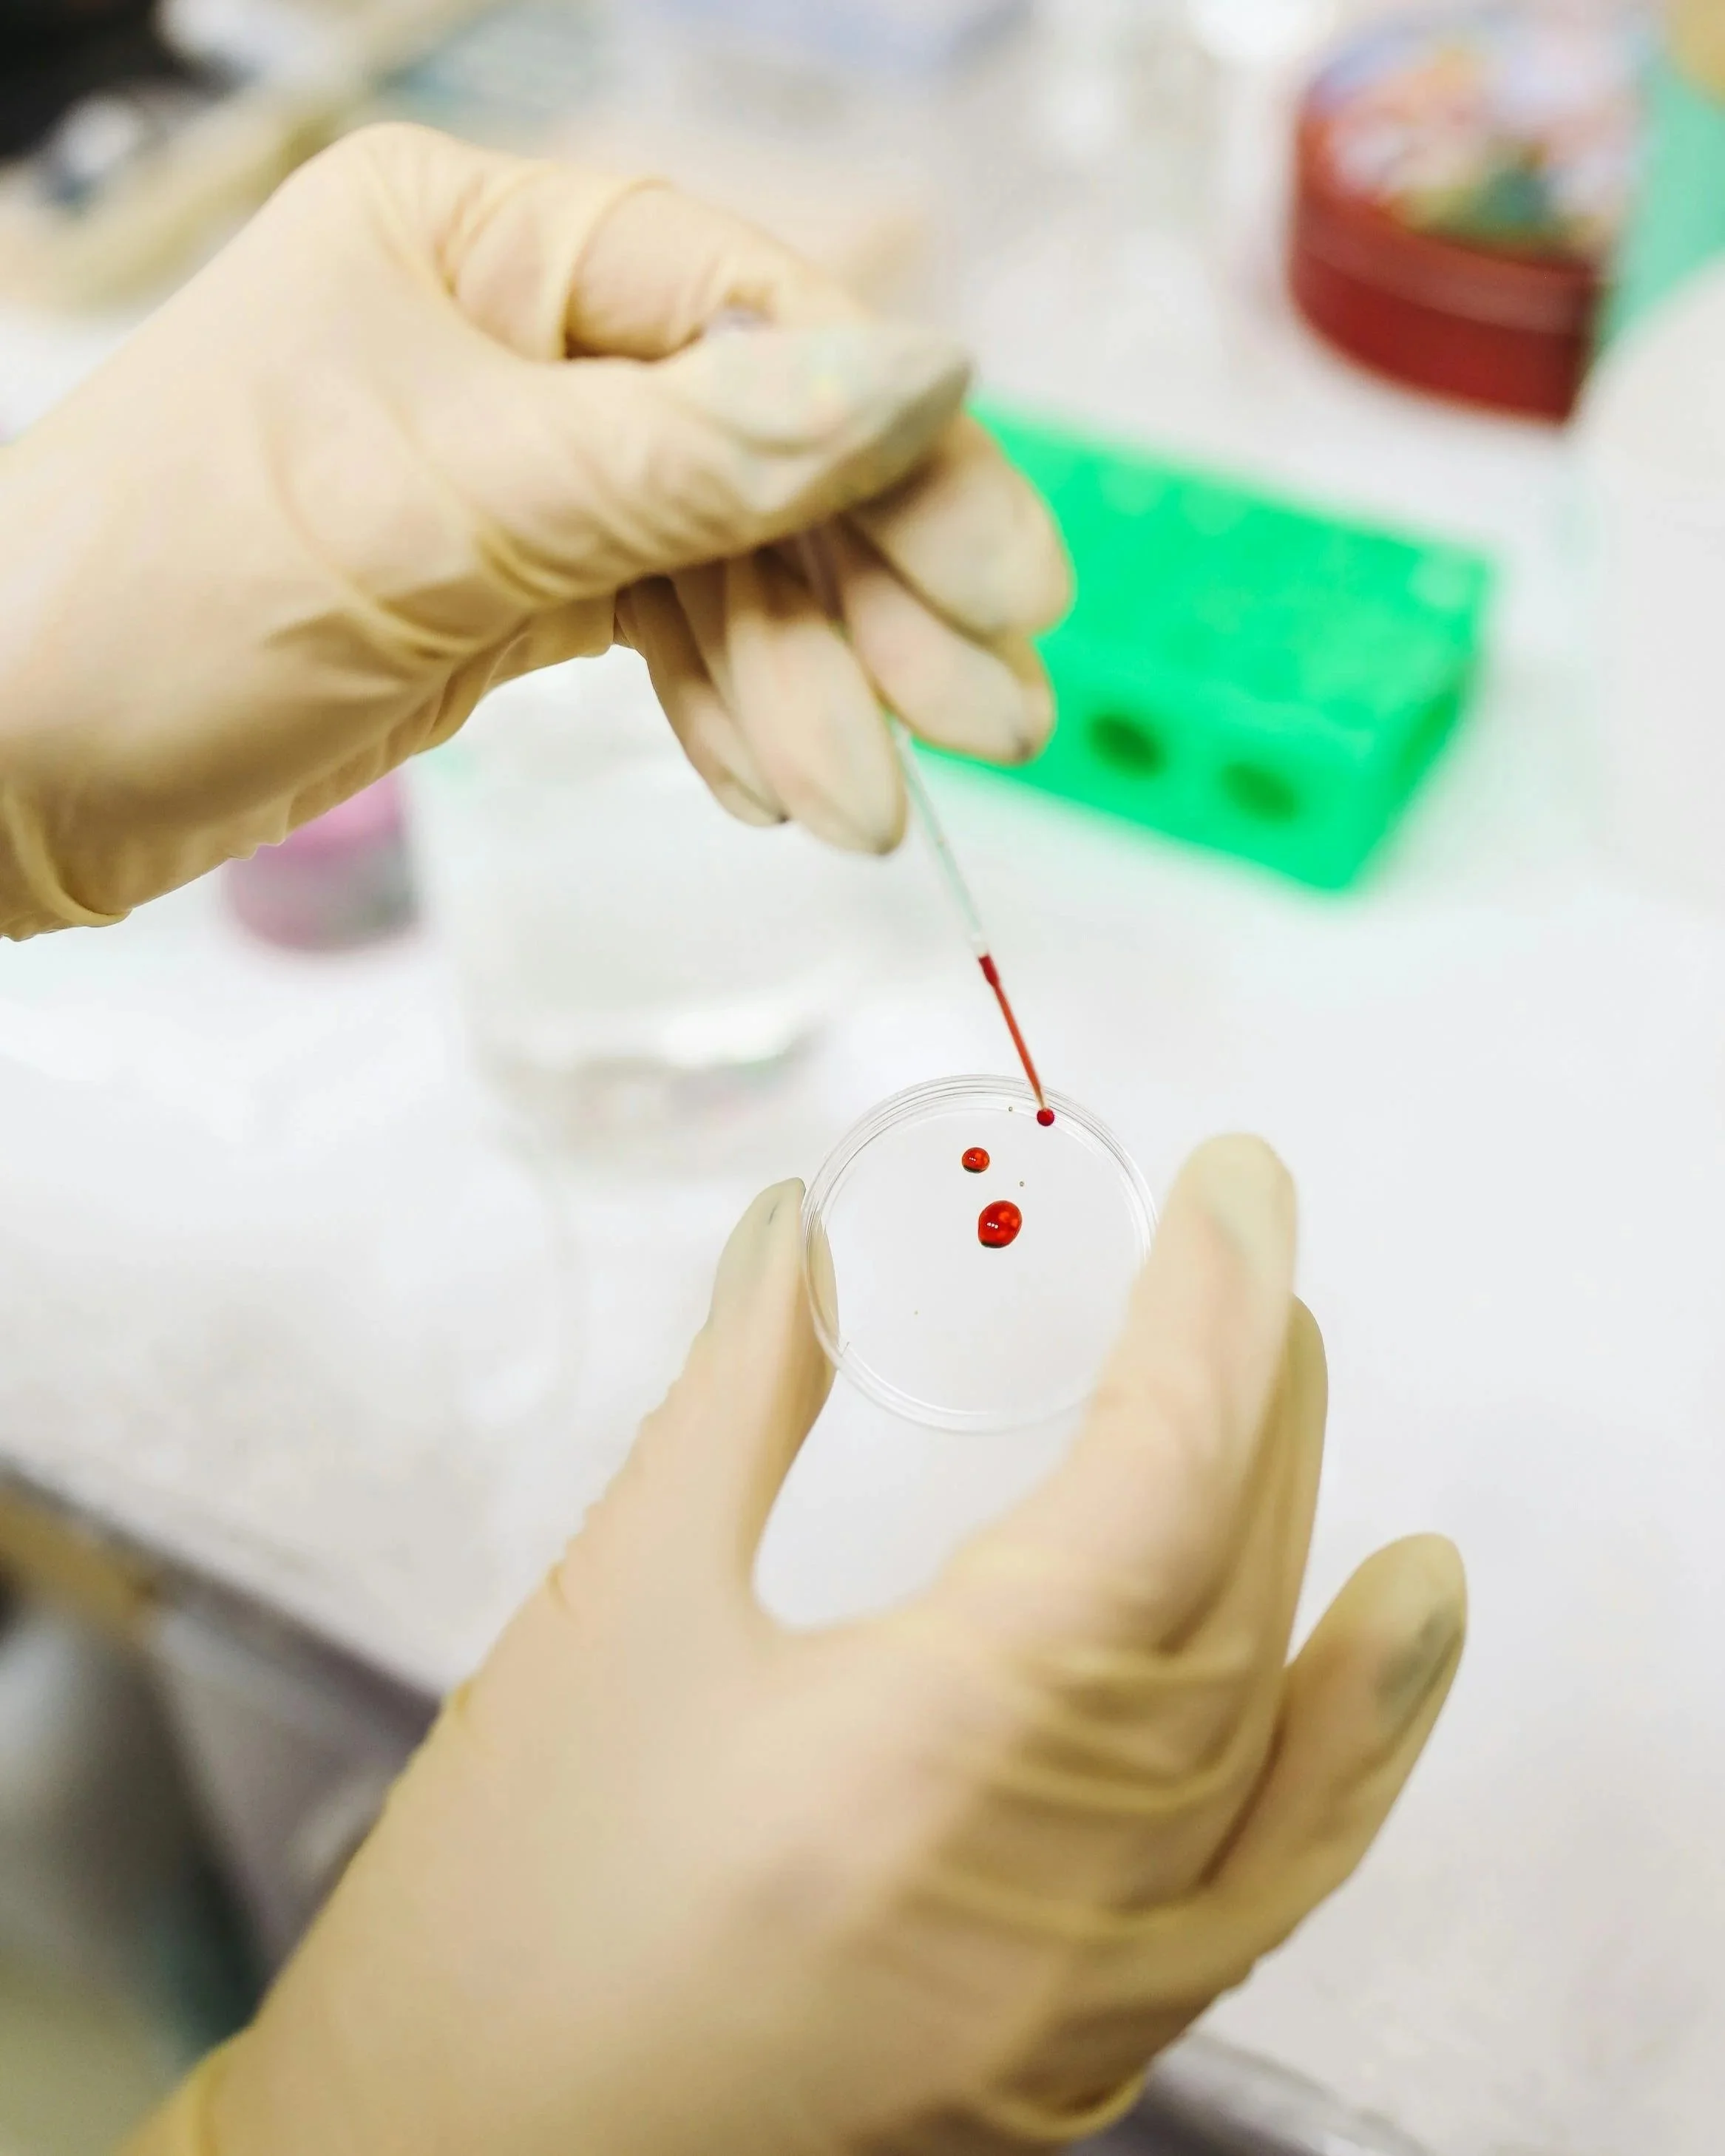
CAR-T Therapy: Redefining the Future of Medicine

From Biochemistry to the Bar: When Scientists become Protectors of Innovation

Where Psychology Meets Space: An Interview With Dr. Raphael Rose

From Kenya to UCLA: The Journey and Insights of Statistician Samuel Onyancha Onyambu

Mind into Matter: How Susan Aldworth turns Brain Scans into Art
CAR-T Therapy: Redefining the Future of Medicine

Inside the Ring: The Little-Known Medical Specialty Safeguarding Combat Sports

Learning Beyond the Lecture: How UCLA’s Learning Assistant Program Transforms Large Classes

Poornima Peiris: Leading Hope For the Future of STEM

Engineering Change: Empowering Women to Succeed in STEM at UCLA

Interview with Malvika Iyer, Editor-In-Chief of UCLA's Undergraduate Science Journal

So You Want to Pursue a PhD? Here’s What You Need to Know About Applying to Grad School
Maria Kesisoglou

Beyond Compliance: What Accessibility Still Misses for Disabled People and Their Families
Elizabeth Cotillo

When Medicine Plays God: Why Bioethics Still Matters
Annette Byun

A Life in Discovery: Professor Paraskevi Papadopoulou’s Journey from UCLA to Global Science Leadership
Elena Ponichtera

Humza Khan: From UCLA pre-med to Stanford MD/PhD
John Mason

From Cells to Service: Dr. Geschwind at the Center for Autism Research and Treatment
Micaela White
